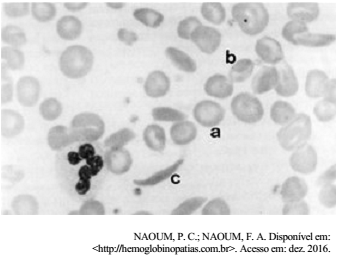
Enunciado 642152-1

Foram encontradas 575 questões.
Acerca dos fatores que influenciam diretamente nos
resultados de hemoculturas, assinale a alternativa correta.
Provas
Questão presente nas seguintes provas
De acordo com a Norma Regulamentadora 32 (NR 32), para
assegurar melhor rendimento e qualidade de vida para o
colaborador e para o meio ambiente, deve-se implementar os
seguintes programas:
Provas
Questão presente nas seguintes provas
O teste SeptiFast consiste em um método molecular de
amplificação in vitro de ácidos nucleicos para
Provas
Questão presente nas seguintes provas
![]()
Com base no perfil sorológico apresentado, é correto afirmar que se trata de um quadro de
Provas
Questão presente nas seguintes provas

Essa figura mostra uma microscopia de luz de um exame histopatológico de pulmão, em que se identifica(m)
Provas
Questão presente nas seguintes provas

Considerando a figura apresentada, que mostra o antígeno H servindo de estrutura básica para a formação dos antígenos A e B, assinale a alternativa que corresponde às respectivas terminações que caracterizam esses dois últimos.
Provas
Questão presente nas seguintes provas
A microscopia de luz apresentada mostra um mesmo elemento celular sanguíneo em três estágios (a, b, c) em processo de
Provas
Questão presente nas seguintes provas
Durante uma transfusão sanguínea, deve-se ter cuidado quanto à
reação transfusional, que pode ser tardia ou imediata. A esse
respeito, é correto afirmar que pode ser considerada reação
transfusional imediata a
Provas
Questão presente nas seguintes provas
Com relação à transfusão pediátrica, assinale a alternativa
correta.
Provas
Questão presente nas seguintes provas
A criopreservação de células progenitoras hematopoéticas deve
ser realizada de forma que não haja perda das funções das
células. Assim, deve-se levar em consideração alguns fatores,
tais como: volume, concentração de células, velocidade de
congelamento, e também o agente crioprotetor a ser usado. Com
base nessas informações, assinale a alternativa que indica
substâncias que podem ser crioprotetoras.
Provas
Questão presente nas seguintes provas
Cadernos
Caderno Container